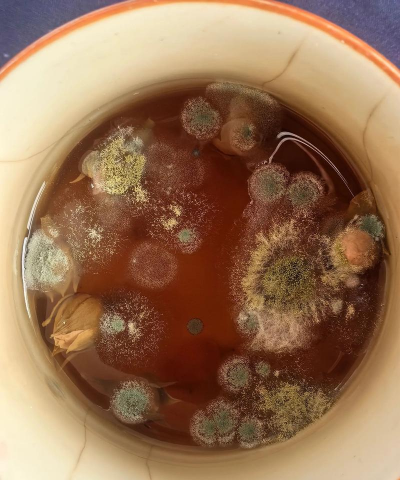

养花用的细菌
在养花过程中,使用细菌有一定的应用,但需注意其使用方法和安全性。以下是常见的养花用细菌及其应用方式:
1. 根瘤菌(Rhizobia)
用途:
根瘤菌能够与豆科植物的根系共生,帮助植物固定大气中的氮气,提高土壤肥力。适用于豆科植物的种植。
使用方法:
- 在播种前,将根瘤菌菌种与土壤混合,或在种植豆科植物时,将菌种直接撒入土壤中。
- 也可通过菌剂(如根瘤菌肥料)施用于植物根部。
注意事项:
- 需要确保土壤中有足够的水分和养分。
- 适合用于豆科植物,如大豆、豌豆、苜蓿等。
2. 假单胞菌(Pseudomonas)
用途:
假单胞菌在植物病害防治中具有重要作用,能够抑制病原菌的生长,预防或减轻植物病害。
使用方法:
- 作为生物防治剂,可喷洒在植物叶片上,或拌入土壤中。
- 适用于多种植物,尤其是容易受害的作物。
注意事项:
- 需要根据具体病害选择合适的菌种。
- 使用时需注意浓度,避免对植物造成伤害。
3. 硝化细菌(Nitrosomonas / Nitrobacter)
用途:
硝化细菌能够将氨转化为硝酸盐,促进植物对氮的吸收,提高土壤肥力。
使用方法:
- 与根瘤菌一起使用,提高氮素转化效率。
- 可以作为菌肥施用于植物根部。
注意事项:
- 适合用于富含有机质的土壤。
- 需要配合其他微生物共同作用,效果更佳。
4. 菌根真菌(Ecto/Endo-Fungi)
用途:
菌根真菌与植物根系共生,增强植物对水分和养分的吸收能力。
使用方法:
- 作为有机肥料或土壤改良剂,撒入土壤中。
- 也可与植物根部混合使用,增强植物抗逆性。
注意事项:
- 需要选择适合当地气候和植物种类的菌根真菌。
- 使用时需注意土壤湿度和温度。
5. 其他有益细菌
- 枯草芽孢杆菌(Bacillus subtilis):用于防治病害,促进植物生长。
- 蜡质芽孢杆菌(Bacillus pumilus):用于改善土壤结构,提高土壤肥力。
- 荧光假单胞菌(Pseudomonas fluorescens):用于生物防治,抑制病原菌。
总结
在养花过程中,使用有益细菌可以提高植物健康、促进生长、改善土壤质量。但需根据具体植物种类和病害情况选择合适的菌种,并注意使用方法和浓度,以避免对植物造成伤害。
如果需要更具体的建议,欢迎提供植物种类和问题,我可以为你提供更详细的指导。
养花怎样去飞虫
在养花过程中,飞虫是常见的问题,尤其是蚜虫、红蜘蛛、白粉虱等。以下是几种常见的防治方法,适用于大多数家庭养花场景:定期检查植物:每天或每周检查植物叶片和茎干,及时发现虫害迹象。手工清除:对于小规模的虫害,可以用棉签或软毛刷清除虫体和虫卵。喷
· 2025-11-22
雨季养花的技巧
雨季养花的技巧雨季是植物生长的重要时期,但同时也可能带来水分过多、土壤排水不良等问题。以下是雨季养花的实用技巧:避免积水:雨季土壤容易积水,导致根部缺氧,影响植物生长。应根据土壤湿度决定浇水时间,避免在雨天或土壤湿润时浇水。晴天早晨浇水:在
· 2025-11-22
周末养花的好处
周末养花的好处放松身心,缓解压力养花是一项轻松的活动,能够帮助人们放松心情,缓解工作和生活中的压力。在周末,可以专注于照料植物,享受宁静的时光,有助于改善情绪和提升幸福感。提升生活品质养花不仅能美化家居环境,还能带来视觉上的愉悦感。通过精心
· 2025-11-22
男人需要养花吗
养花对于男人来说,并不是必须的,但养花可以带来许多好处,比如放松心情、提升生活品质、促进身心健康等。以下是一些关于养花的建议和知识,供参考:放松心情:养花是一项有节奏的活动,有助于缓解压力,提升情绪。提升生活品质:通过种植花草,可以增加生活
· 2025-11-22
自己制作养花箱
制作一个简易的养花箱可以利用日常材料,既环保又经济。以下是几种常见且实用的制作方法:方法一:木箱改造材料:废旧木箱(如旧衣柜、木桶、木箱等)步骤:去除木箱的多余部分,保留箱体结构。如果需要,可以将木箱切割成适当尺寸,确保箱体稳固。用木板或胶
· 2025-11-22
小黑球养花方法
小黑球,又称黑藻,是一种常见的水生植物,常用于水培或水槽中作为观赏植物。在养花时,小黑球的种植和养护方法如下:选择容器使用透明的玻璃杯或塑料容器,便于观察水中的植物生长。配制营养液可以使用市售的水培营养液,或自行配制: 1升水加1茶匙有机
· 2025-11-22
养花人吃西瓜
养花人吃西瓜?这听起来不太对劲。西瓜是水果,属于植物的果实,通常用于食用,而不是用于养花。如果你是想问“养花人吃瓜”或者“养花人吃西瓜”,可能需要澄清一下。如果问题确实是“养花人吃西瓜”,那么可能有以下几种理解:养花人吃西瓜:这可能是指养花
· 2025-11-22
怎么好好保养花
保养花需要根据不同的植物种类和生长阶段进行调整,以下是一些通用的保养建议:适量浇水:根据植物种类和季节调整浇水频率。通常,土壤表面干燥后再浇水为宜。避免积水:防止根部腐烂,尤其是多肉或盆栽植物。不同植物需求不同:如多肉植物需少量多次,而苔藓
· 2025-11-22
顶楼露台能否养花
在顶楼露台养花是可行的,但需要考虑一些关键因素,以确保植物健康生长。以下是一些需要关注的要点:顶楼露台的光照情况因地区和季节而异。一般来说,如果露台有充足的阳光(每天6小时以上),适合种植喜阳植物,如多肉、玫瑰、向日葵等。如果光照不足,可以
· 2025-11-22
辛集养花基地
辛集作为河北省的一个重要城市,拥有一定的农业发展基础,尤其是在花卉种植方面。以下是一些关于辛集养花基地的相关信息和建议:辛集是河北省石家庄市下辖的一个县级市,地处华北平原,气候温和,四季分明,适合多种花卉的种植。近年来,随着人们对绿化和花卉
· 2025-11-22